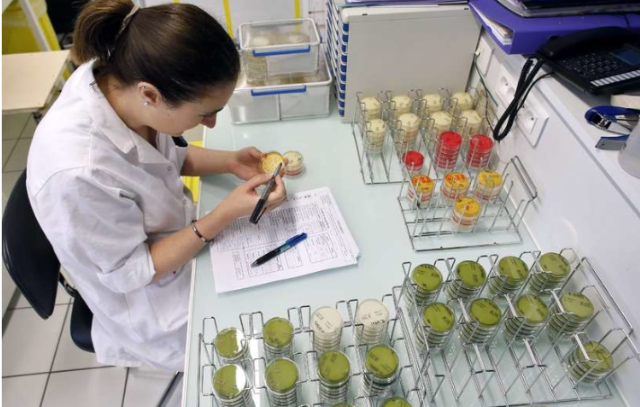

An experienced professional with planning and organizational skills that balance work, team support and ad-hoc responsibilities in a timely and professional manner.
I thrive in a busy environment with time pressures while I am a structured and analytical individual who provides service at a high level. I do work independently, but function well in team atmosphere, with a positive attitude and a good sense of humour.
| Jon Tryggvi Sveinsson | Points |
|---|---|
| Academic | 0 |
| Author | 1 |
| Influencer | 26 |
| Speaker | 0 |
| Entrepreneur | 20 |
| Total | 47 |
Points based upon Thinkers360 patent-pending algorithm.
Superb scientific output from research in Iceland
Superb scientific output from research in Iceland
Tags: Leadership
 Leadership Management International, Inc.
Leadership Management International, Inc.
Tags: Leadership, Management
 Leadership Management International, Inc
Leadership Management International, Inc
Tags: Leadership